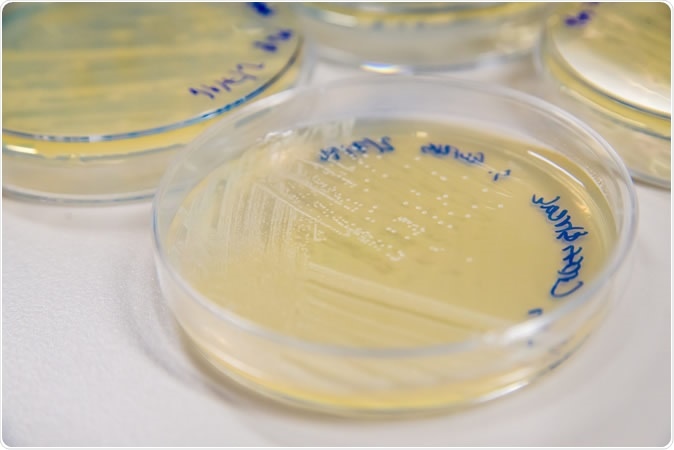
Methicillin-Resistant Staphylococcus aureus (MRSA) cross-streak culture on an agar plate. Image Credit: SubstanceTproductions / Shutterstock

It is important to discover antibiotic drugs and to bring them to clinical use, a task made all the more urgent by the increase in the number of infections that are resistant to existing antibiotics. However, this task is a formidable one.
The very first antibiotic was penicillin, discovered about 100 years ago. This simple drug transformed medical practice and brought antibiotics to the very forefront of modern medicine. It enabled doctors to bring about near-miraculous cures and made surgery an almost-always curative procedure rather than one which killed the patient in most cases. The role of antibiotics in preventing and treating infection has made even complex hip replacements and organ transplants a daily reality.

Penicillin fungi in petri dishes. Image Credit: science photo / Shutterstock
The flip side – antibiotic resistance
However, like so many good things, humans have overused and misused antibiotics to the point that many bacteria (called ‘superbugs’) have learned how to out-maneuver them by using and passing on genes to resist or bypass the effects of specific antibiotics or antibiotic classes. This is termed drug resistance and it is growing by leaps and bounds, because of the use of antibiotics without sufficient indication, either to prevent infections in animals, people and plants, to promote growth, or their unnecessary use to treat viral or minor bacterial infections. About half of antibiotic prescriptions in the 34 countries in the Organization for Economic Cooperation and Development (OECD) were inappropriately used! And 17% of bacterial infections in these countries are now resistant – though this figure goes up to up to 60% of infections in India, Brazil and Russia.
As drug-resistant infections are on the rise everywhere, and are threatening public health on a major scale, the discovery of new antibiotics capable of countering the counter-attack by these organisms has become an emergency. Without this, modern medicine will slide back rapidly to the dark ages where infection reigned almost uncontested. Even today, 700,000 lives fall prey to antibiotic resistance. Yet 6,000,000 people die of untreated infections at the same time!
Urinary infections, newborn infections and chemotherapy, to take just a few instances, are becoming rapidly unsafe because of the lack of working antibiotics to counter just five bacteria, including Escherichia coli (E. coli), methicillin-resistant Staphylococcus aureus (MRSA), and Klebsiella pneumoniae. Drug-resistant tuberculosis is another huge challenge, with over half a million cases at present, posing a high risk of infection to children.
Methicillin-Resistant Staphylococcus aureus (MRSA) cross-streak culture on an agar plate. Image Credit: SubstanceTproductions / Shutterstock
Even when new antibiotics are developed, eventually resistance will crop up to them as well, making it necessary to constantly come up with new preventive and diagnostic methods, as well as control and surveillance of contagious infections.
The obstacles to new antibiotics
It is a notable fact that the last discovery of an antibiotic class – a category of antibiotics that all have the same mechanism of action and affect the same type of bacteria – was in the 1980s. Since then, every new antibiotic has been just an improved form of an existing one. This is because the process of developing a new antibiotic is expensive, takes a lot of time and effort, requires intensive scientific knowledge, and has a huge number of failures compared to the few successes.
To put things in a more concrete perspective, the development of a single new antibiotic may involve costs of over a billion dollars and a time period of well over a decade or even 15 years.
Why so costly - the stages of drug development
The first step is to find organisms that synthesize antibiotics – these may be identified in a variety of unexpected locations – imagine antibiotic-producing bacteria in your nose, in the blood of Komodo dragons, or inside ants!
The possible compounds need to be isolated and tested to assess their effectiveness against bacteria toxic to humans, and also to ensure they do not harm humans.
Candidate drugs are identified at the end of this preclinical testing stage, and are then tested clinically for effectiveness and safety in humans.
Clinical testing occurs in 4 phases:
- the first (phase 0) for safety in a very small number of patients
- the second (phase I) for a larger number of patients without any health conditions, to see how high a dose can be tolerated without serious adverse effects, and for the optimal route of administration
- the third phase, Phase II, for efficacy in several hundred people with the illness for which the new drug is meant, who are treated with the dose determined to be safe in phase I in order to know more about how the drug interacts with the body
- Phase III, a large trial involving up to 3000 people with the health condition that the drug is intended to treat, who are randomly treated with the new drug or an existing treatment in equal numbers, to demonstrate it is at least as safe and as effective as an existing medication.
Thus, clinical trials may consume up to 80% of the total costs of developing a new antibiotic due to the immense infrastructure, expertise and resources required.
Finally, the drug must be licensed by a government agency in charge of regulating drugs that can be legally prescribed in that country. This requires an appraisal of the technology and trial results, a slow and cumbersome process, adding to the costs and the delay.
Breaking the economic back of antibiotic R & D
Once the drug is legally available, it requires to be marketed to doctors and to health systems, to enhance their adoption. However, today pharma firms direct their efforts towards making them aware of the new drug but cannot encourage its use until it is required as a last resort, in order to prevent new drug resistance from emerging. This severely limits the profitability of the new drug – and antibiotics are already notorious for their low margin of profit compared to other medicines.
In short, with the current state of affairs, no pharmaceutical can hope to recover the huge costs of new antibiotic development. Most large firms – which are the only ones that are equipped for clinical trials – are already out of the arena. In fact, today only a few firms are involved in developing new antibiotics, though there were 18 in the 1980s. And most of these are small biotech firms.
The way ahead
The funding approach is changing from corporate funding of research to government-philanthropic partnerships, but the big question of how to make antibiotic research and development profitable still remains.
At present, 40-50 antibiotics are being developed, but most do not have significant advantages over the current treatments, and few are effective against Gram-negative bacteria, the most dangerous of antibiotic-resistant bacteria. Many more, up to 250 candidates, are in the early phases of testing, but over a decade must pass before even the few (1 in 30) that will make it all the way through reach the market.
To make antibiotic development a sustainable process, there must be an incentivized pathway. This may be achieved in different ways, such as offering rewards for successful market entries, or the UK’s pilot program of subscribing to a development program by a pharma company based on the estimated usefulness of the drug to its National Health System. Government-run antibiotic stockpiles are another option. However, programs that depend on government support have so far met with a lukewarm response.
Antibiotic-manufacturing companies have also shown signs of change such as not promoting sales by offering bonuses, educating professionals about the spread of resistant infections and enhancing access to new antibiotics where they are needed.
However, new models will be needed which distribute not just the expertise and the antibiotics, but also the risk, across the pharma industry, the government and philanthropy, for an equitable answer to the current dilemma.
Journal references:
Wellcome.ac.uk. (2020). Why is it so hard to develop new antibiotics? -https://wellcome.ac.uk/news/why-is-it-so-hard-develop-new-antibiotics
Wellcome.ac.uk. (2020). What are drug-resistant infections? - https://wellcome.ac.uk/news/what-are-drug-resistant-infections